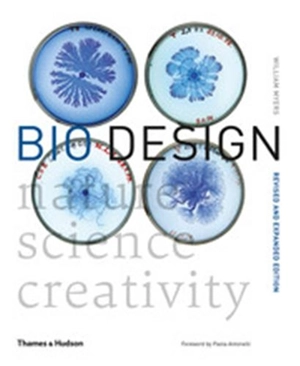
Bio Design (New ed) - William Myers

Bio Design (New ed)
William Myers , Paola Antonelli
Thames & Hudson
|
juillet 2018
33.25 €
-5% pour les titulaires de la carte
info
avec le retrait en librairie
LIBRAIRIES PARTICIPANTES
Paris VIᵉ, Paris VIIIᵉ, Paris XVIIᵉ, Paris Vᵉ
Versailles, Lyon 2ᵉ, Lyon 6ᵉ...
Versailles, Lyon 2ᵉ, Lyon 6ᵉ...
Voir les disponibilités en librairie
Caractéristiques Auteur(s) Éditeur(s) Date de parution
1 juillet 2018
Rayon
Arts décoratifs
EAN
9780500294390
Nombre de pages
304
pages
Reliure
Broché
Dimensions
26.0
cm x
21.0
cm x
2.5
cm
Poids
1200
g
|










